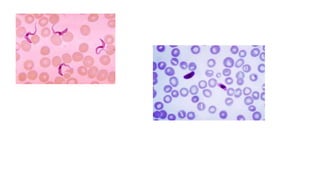

This document provides information about cell biology and different types of cells. It begins by outlining the cell theory. It then discusses unicellular and multicellular organisms. It describes the key differences between akaryotes (viruses), prokaryotes (bacteria), and eukaryotic cells (plant and animal cells). The document discusses the structures and functions of organelles in eukaryotic cells. It provides examples of specialized cells like sperm, muscle, and red blood cells. In the end, it provides exercises for students related to topics covered.